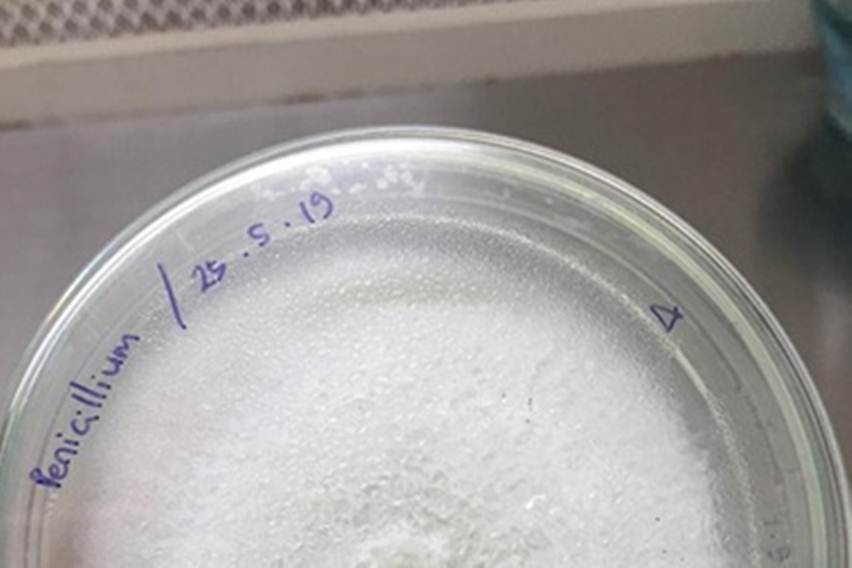
Cendawan endofit

Trubus.id — Cendawan endofit Dark Septate Endophytes (DSE) merupakan cendawan yang memiliki peran penting bagi tanaman dan lingkungan.
Menurut Surono, Ph.D., Peneliti Pusat Riset Mikrobiologi Terapan, Badan Riset dan Inovasi Nasional (BRIN), peran DSE sangat penting di tengah permasalahan perubahan iklim. Peran DSE perlu ditelusuri dan dipahami karena tidak ada tumbuhan di lingkungan yang tidak bersimbiosis dengan mikroba.
“Peran mikroba seperti DSE ini bisa menjadi penyelamat lingkungan, terutama untuk mengembalikan unsur hara di dalam tanah. Potensi cendawan endofit ini juga sering muncul di berita dan berbagai publikasi riset, terutama terkait fungsinya dalam pengendalian cekaman abiotik dan biotik,” tutur Surono.
Mengutip dari laman IPB University, Surono mengatakan, adanya perubahan iklim membuat peneliti ditantang untuk mampu memitigasi (dampaknya) agar tidak semakin luas. Terutama, dampak akibat kekeringan, kebanjiran, dan naiknya suhu bumi.
Cendawan DSE dilaporkan masuk dalam kelas endofit akar dan bersifat non-pathogen. Keuntungannya adalah dapat memacu pertumbuhan dan peningkatan adaptasi tanaman terhadap cekaman biotik dan abiotik, menunjang ketersediaan unsur hara di kondisi tertentu, serta mendorong produksi fitohormon dan metabolit sekunder.
Ia menambahkan, pengendalian hayati dan cekaman dengan DSE ini masih memiliki banyak ruang untuk dieksplorasi. Salah satu pengendalian hayatinya yakni mampu menekan fitopatogen seperti fusarium pada tomat. Sementara itu, pada tanaman sawit dapat menekan pertumbuhan ganoderma.
Karakteristik khusus DSE dibanding cendawan lainnya adalah kemampuan mengolonisasi akar tanaman inang, baik inter maupun intraseluler. Cendawan ini tidak menunjukkan efek negatif pada tanaman inang, bahkan mampu memacu pertumbuhan tanaman inang di bawah cekaman biotik dan abiotik.
“Cendawan ini sering bersimbiosis dengan tanaman pangan. Di Indonesia masih perlu eksplorasi lagi karena masih sedikit pemanfaatannya,” tutur Surono.
Menurutnya, tanaman yang diberikan perlakuan oleh DSE memiliki pertumbuhan yang lebih baik dibanding tanaman kontrol. Kendati demikian, ia menilai perlu ada pendalaman terkait metabolomiknya dan senyawa-senyawa sekunder yang berpotensi dapat dimanfaatkan di dunia industri ataupun perkebunan untuk pengendalian hayati di lapangan.
Lebih lanjut, ia menekankan, pemanfaatan DSE sebagai sumber daya hayati di masa depan sangat berguna untuk pertanian organik atau pertanian ramah lingkungan. Pemanfaatan ini perlu didorong untuk menghasilkan produk pertanian yang lebih sehat dan berkualitas serta biaya produktivitas usaha tani yang lebih efisien.